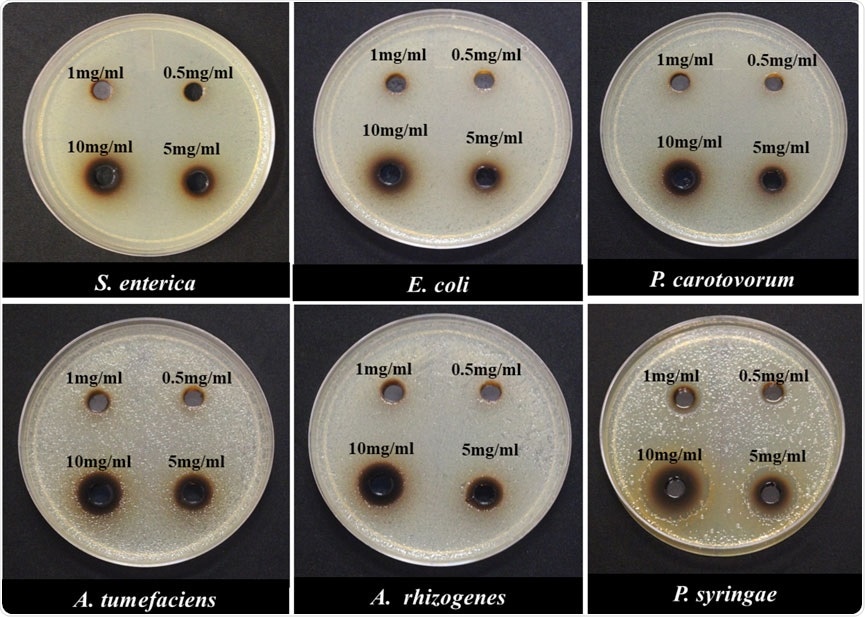
Minimum inhibitory concentration (MIC) of Gram-negative bacterial species in response to different concentrations of NH2-FCDs using the agar-plate well diffusion method.

The researchers provided the optimal concentration and incubation times for each bacterial species. They found that not all carbon dots carry antimicrobial properties. Interestingly, they observed that there is a variation between different bacterial species in how their resistance plays against these carbon dots.
 Study: Amine-Coated Carbon Dots (NH2-FCDs) as Novel Antimicrobial Agent for Gram-Negative Bacteria. Image Credit: Rost9 / Shutterstock.com
Study: Amine-Coated Carbon Dots (NH2-FCDs) as Novel Antimicrobial Agent for Gram-Negative Bacteria. Image Credit: Rost9 / Shutterstock.com
Introduction
According to the World Health Organization (WHO), antibiotic resistance is one of the greatest health threats globally. Due to the widespread availability of various antibiotics and the exposure of the bacteria to these drugs for extended periods of time, MDR can easily develop in bacteria.
The United States Centers for Disease Control and Prevention (CDC) Annual Threat Report for 2019, shows more than 2.8 million antibiotic-resistant infections currently exist worldwide. The report highlights the human death toll of up to 35,000 due to MDR in the United States.
Therefore, alternative antimicrobial strategies need to be developed. One of the promising approaches is the use of photodynamic inhibition (PDI) properties of materials, which causes nonspecific oxidative damage to vital molecules inside the bacteria.
This process, which is also known as photodynamic therapy (PDT), locally releases free radicals such as reactive oxygen species (ROS) and reactive chlorine species (RCS) produced by a photosensitizer (PS) into the infected cells. All bacteria, including MDR bacteria, are therefore killed in the process.
Importantly, because the bacteria do not develop resistance to PDT, this method is a useful antibacterial strategy. However, current PDI compounds are associated with some limitations including poor photostability, poor water dispersibility, and an inability to be absorbed in the region. In this context, carbon nanoparticles (carbon dots) are considered novel PDI compounds with excellent photostability and autofluorescence properties.
Carbon dots (CDs) are zero-dimensional photoluminescent particles that have a diameter of fewer than 20 nanometers (nm). CDs produce ROS, which can be effectively used against bacteria. The mechanism of action by CDs may include their adhesion to the bacterial surface, disruption of the bacterial cell wall, random oxidative damage to nucleic acids and proteins, altering the gene expression patterns, and affecting other biomolecules.
Different CDs from diverse origins are synthesized and tested against bacteria. In the present study, the researchers evaluate four different carbon dots that were reported for cell imaging for their antibacterial properties.
Study findings
The researchers synthesized 4 CDs including amine-coated carbon dots (NH2-FCDs), synthesized from glucosamine HCL (GlcNH2·HCl) and 4,7,10-trioxa-1,13-tridecanediamine (TTDDA), carboxyl-coated carbon dots (COOH-FCDs) that consist of glucosamine and b-alanine, nitrogen-coated carbon dots (N-CDs) that consist of glucose and L-arginine, and polyethyleneimine functionalized (PEI)-carbon dots that consist of citric acid and PEI.
The researchers characterized the functional groups of the CDs using Fourier transform infrared spectroscopy – attenuated total reflectance (FTIR-ATR) analysis. They also studied photoluminescence properties including absorbance, emission, and excitation wavelength, and measured the electrostatic charges carried by CDs.
Minimum inhibitory concentration (MIC) of Gram-negative bacterial species in response to different concentrations of NH2-FCDs using the agar-plate well diffusion method.
To test for antimicrobial properties, the researchers performed the agar plate well-diffusion method to determine the minimum inhibitory concentration (MIC) of NH2-FCDs with different concentrations of CDs from 0.5, 1, 5 to 10 mg/ml. They used six bacterial strains belonging to different taxonomic groups, of which included E. coli (DH5α), Pectobacterium carotovorum (Ecc7), Agrobacterium tumefaciens (EHA101), Agrobacterium rhizogenes (K599), Pseudomonas syringae, and Salmonella enterica subsp. enterica serovar Typhimurium.
The researchers found that all the CDs, except PEI-CD, had differing degrees of bacterial growth inhibition at different concentrations. At higher concentrations, more inhibition was observed.
Using confocal microscopy, the researchers established the mechanism of the antibacterial action in that the CDs interacted with the bacterial cell surface, which resulted in the complete dissolution of the membrane. Even after multiple washing steps, they reported adherence of the CDs to the cell membranes. In the case of the sensitive Pseudomonas bacteria, zero colonies were observed after an incubation time of one hour.
Testing both the precursor solutions and the CDs against the bacteria, the antimicrobial capacity was found to be enhanced in the NH2-FCDs and not the precursors.
The researchers further tested for the incubation time for complete inhibition of bacterial cells. Depending on the species, different bacterial strains required different incubation times for complete inhibitions by NH2-FCDs.
In conclusion the researchers said, "Considering the antibiotic properties of these carbon dots against Agrobacterium which is a common tool in the delivery of foreign DNA into plants, this carbon dot can be used for the eradication of Agrobacterium from the cell and tissue culture media, instead of common antibiotics that are used for this purpose."
Journal reference:
- Devkota, A., Pandey, A., Yadegari, Z., et al. (2021). Amine-Coated Carbon Dots (NH2-FCDs) as Novel Antimicrobial Agent for Gram-Negative Bacteria. Frontiers in Nanotechnology. doi:10.3389/fnano.2021.768487.